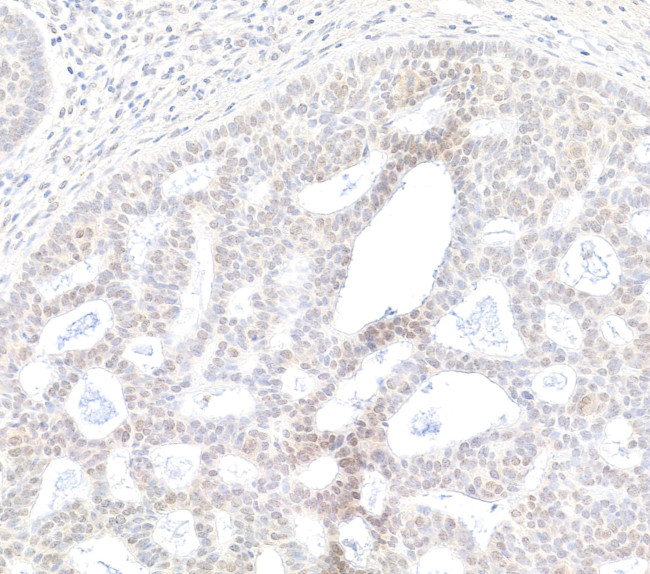
BRD2 Antibody in Immunohistochemistry (Paraffin) (IHC (P))

Search
Bethyl Laboratories
BRD2 Polyclonal Antibody
{{$productOrderCtrl.translations['antibody.pdp.commerceCard.promotion.promotions']}}
{{$productOrderCtrl.translations['antibody.pdp.commerceCard.promotion.viewpromo']}}
{{$productOrderCtrl.translations['antibody.pdp.commerceCard.promotion.promocode']}}: {{promo.promoCode}} {{promo.promoTitle}} {{promo.promoDescription}}. {{$productOrderCtrl.translations['antibody.pdp.commerceCard.promotion.learnmore']}}
产品信息
A302-583A
种属反应
宿主/亚型
分类
类型
抗原
偶联物
形式
浓度
规格
纯化类型
保存液
内含物
保存条件
运输条件
产品详细信息
The recommended shelf life for this product is 1 year from date of receipt.
Application Note: For IHC, epitope retrieval with citrate buffer pH 6.0 is recommended for FFPE tissue sections.
Based on 100% sequence identity, this antibody is predicted to react with Bovine and Dog
靶标信息
This gene encodes a transcriptional regulator that belongs to the BET (bromodomains and extra terminal domain) family of proteins. This protein associates with transcription complexes and with acetylated chromatin during mitosis, and it selectively binds to the acetylated lysine-12 residue of histone H4 via its two bromodomains. The gene maps to the major histocompatibility complex (MHC) class II region on chromosome 6p21. 3, but sequence comparison suggests that the protein is not involved in the immune response. This gene has been implicated in juvenile myoclonic epilepsy, a common form of epilepsy that becomes apparent in adolescence. Multiple alternatively spliced variants have been described for this gene, but the full-length nature of some of these variants has not been determined.
仅用于科研。不用于诊断过程。未经明确授权不得转售。
篇参考文献 (0)
生物信息学
蛋白别名: BRD2 intronic transcript 1; Bromodomain-containing protein 2; DADB-17J1.3; DKFZp686N0336; female sterile homeotic-related gene 1; Female sterile homeotic-related protein 1; FLJ31942; FSH; Fsrg-1; KIAA9001; O27.1.1; putative; really interesting new gene 3 protein; RING3 protein
基因别名: AW228947; BRD2; BRD2-IT1; D17H6S113E; D6S113E; Frg-1; FSH; FSHRG1; Fsrg-1; FSRG1; Kiaa4005; KIAA9001; mKIAA4005; NAT; O27.1.1; RING3; RNF3
UniProt ID: (Human) P25440, (Mouse) Q7JJ13
Entrez Gene ID: (Human) 6046, (Mouse) 14312